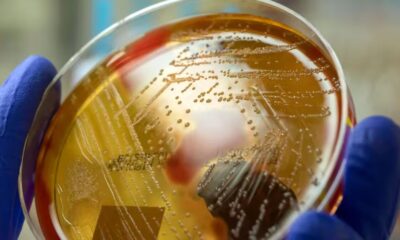
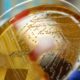

Este choque define quién obtendrá el codiciado pase a la Copa América 2024, un evento que promete ser épico.


El entrenador interino ha anunciado su renuncia, dejando la dirección técnica del equipo.


La fiscalía de Perú abrió investigación contra el expresidente Martín Vizcarra.


A través de un breve video difundido en sus redes sociales, ha declarado que dará un importante anuncio.

En Japón, las autoridades sanitarias han levantado la bandera roja ante un notable aumento en los casos de infecciones por Streptococcus.


El Ministerio Público de Honduras ha anunciado a través de sus redes sociales que los fiscales de la Unidad Nacional de Apoyo Fiscal (UNAF) están completamente...


La lucha por el título en la Liga de España se intensifica en el tramo final de la temporada.


Al menos 14 cadáveres aparecieron este lunes por la mañana en la capital de Haití.


La Fiscalía hondureña ha llevado a cabo un operativo de aseguramiento de bienes pertenecientes al expresidente Juan Orlando Hernández.


La diputada Silvia Ayala salió a dar declaraciones sobre lo ocurrido, señalando que había recibido asignación de seguridad debido a varios incidentes previos.